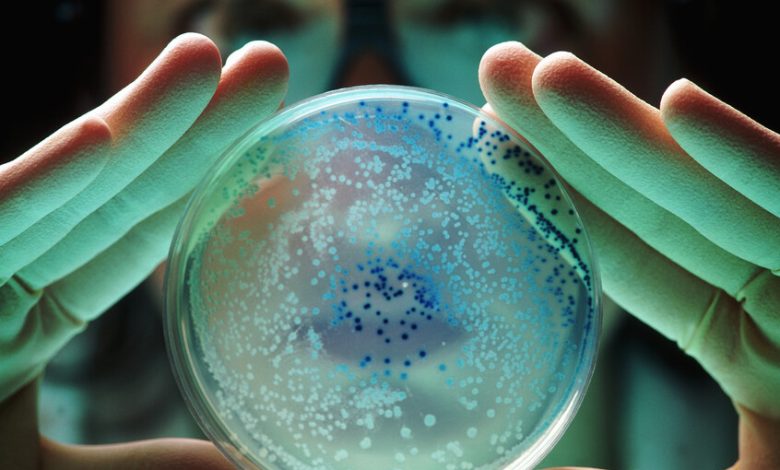

تطوير كائن حي بشفرة وراثية “مختلفة عن أي شي آخر في الطبيعة”!
متابعات
تمكن علماء من تحقيق إنجاز غير مسبوق من خلال تصميم سلالة بكتيرية تحمل شفرة وراثية مختلفة تماما عما هو معروف في الطبيعة، في تطور قد يغير مستقبل الصناعات الدوائية والمواد المتقدمة.
وتم تحقيق هذا الإنجاز من خلال تصميم سلالة بكتيرية تحمل شفرة وراثية مختلفة تماما عما هو معروف في الطبيعة، في تطور قد يغير مستقبل الصناعات الدوائية والمواد المتقدمة.
وهذه البكتيريا المصنعة التي أطلق عليها اسم Syn57، هي نسخة معدلة من بكتيريا الإشريكية القولونية (E. coli) المعروفة بتسببها في التهابات الأمعاء والمسالك البولية. لكن ما يميز هذه النسخة هو اعتمادها على 57 كودونا فقط، مقارنة بالـ64 كودونا التي تستخدمها جميع أشكال الحياة المعروفة.
إقرأ المزيد
ترياق ثوري ينقي الدم من أول أكسيد الكربون في دقيقة واحدة!
ترياق ثوري ينقي الدم من أول أكسيد الكربون في دقيقة واحدة!
ولتبسيط الفكرة، يمكن تشبيه الحمض النووي بكتاب طبخ ضخم، حيث يمثل كل كودون “وصفة” مكونة من ثلاثة أحرف ترشد الخلية إلى كيفية بناء البروتينات.
وقام العلماء بإزالة التكرارات غير الضرورية في هذه الشفرة مع الحفاظ على الوظائف الحيوية الكاملة للبكتيريا.
وهذا التبسيط الجيني يفتح آفاقا غير مسبوقة، حيث يمكن للباحثين الاستفادة من الكودونات المحررة لإنتاج بروتينات ومركبات اصطناعية لم تشهدها الطبيعة من قبل. كما أن البنية الجينية الفريدة تجعل هذه البكتيريا مقاومة للفيروسات التي تعتمد على الشفرة الوراثية التقليدية، وتقلل بشكل كبير من إمكانية اختلاطها مع الكائنات الطبيعية، ما يعزز عوامل الأمان البيولوجي.
ولتنفيذ هذا المشروع الضخم، قسم الفريق البحثي الجينوم إلى 38 قطعة منفصلة، يبلغ طول كل منها نحو 100 ألف حرف وراثي. وتم تركيب هذه القطع باستخدام خميرة كمادة وسيطة، ثم دمجت في البكتيرية الأصلية بتقنية متطورة تجمع بين أداة التعديل الجيني CRISPR-Cas9 وطرق أخرى متقدمة.
وواجه الباحثون تحديات عديدة خلال عملية التطوير، حيث أظهرت بعض المناطق الجينية مقاومة للتغيير أو تسببت في بطء النمو. تم التغلب على هذه العقبات من خلال إعادة ضبط التسلسلات الجينية، وفصل الجينات المتداخلة، واختيار دقيق للكودونات المستبدلة.
إقرأ المزيد
روسيا.. تقنية متقدمة للضمادات النانوية تعزز الشفاء في حالات الطوارئ
روسيا.. تقنية متقدمة للضمادات النانوية تعزز الشفاء في حالات الطوارئ
على الرغم من النجاح في إنشاء الكائن الحي، إلا أن Syn57 تظهر ضعفا واضحا في الأداء. فبينما تحتاج البكتيريا الطبيعية إلى ساعة واحدة لتتضاعف، تحتاج النسخة المصنعة إلى أربع ساعات، ما دفع الخبراء لوصفها بأنها “ضعيفة للغاية”. ويعكف الفريق البحثي حاليا على العمل لتحسين كفاءتها الوظيفية.
ويحمل هذا الإنجاز وعودا كبيرة للمستقبل، حيث يمكن برمجة هذه البكتيريا لإنتاج أدوية مبتكرة، ومواد متطورة، وحتى أشكال حياة اصطناعية تتجاوز ما هو معروف في الطبيعة. كما أن نظامها الجيني الفريد يوفر حماية إضافية ضد انتقال الجينات المعدلة إلى البيئة الطبيعية، حيث ستبدو شفرتها الوراثية وكأنها “لغة غير مفهومة” بالنسبة للكائنات الأخرى.
ويمثل هذا التطور نقلة نوعية في فهمنا لإمكانيات الهندسة الوراثية، ويثبت أن الحياة يمكن أن تستمر بشفرة وراثية أبسط وأصغر، مما يفتح آفاقا للبحث العلمي والتطبيقات الصناعية.
المصدر: ديلي ميل







